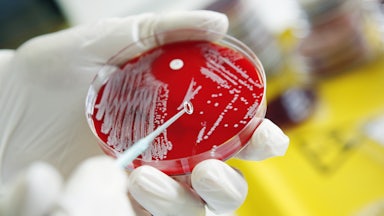

You know the plot: There’s a body. The authorities bungle the case. Those close to the victim are divided about what really happened; conspiracies abound. Then one enterprising amateur takes a second look. Turns out, the crucial clue was hiding in plain sight. Justice may yet be served.
This could be a description of a thousand true crime narratives, from the first season of Serial to the surprise unmasking of the Golden State Killer. But it’s also a rough recounting of Meghan O’Rourke’s 2022 memoir, The Invisible Kingdom—and a growing number of patient narratives in an era of mystery illness.
Medical writing has always contained an element of the whodunit. Physicians are “like Dashiell Hammett’s Sam Spade,” the psychiatrist and medical anthropologist Arthur Kleinman has written. They are trained to see symptoms as “clues to disease, evidence of a ‘natural’ process, a physical entity to be discovered or uncovered.” Neurologist and writer Oliver Sacks, New York Times columnist and real-life Dr. House Lisa Sanders, medical mystery writer Berton Roueché—these are the authorities who brought the clinical case study into the mainstream.
In recent years, however, the structure of the traditional mystery, in which the doctor leads the investigation, has broken down. In particular, patients with chronic health issues, including long Covid, chronic Lyme, and myalgic encephalomyelitis/chronic fatigue syndrome, have found themselves thrust into a debate about whether their conditions exist at all. For these individuals, the medical establishment often provides few answers and even less guidance. By necessity, the patient becomes their own detective.
Meghan O’Rourke, a regular contributor to The New Yorker and The Atlantic, has been investigating her own symptoms for a decade, a search culminating in The Invisible Kingdom. Cheryl Strayed has observed that Porochista Khakpour’s 2018 Sick—her account of life with chronic Lyme—“reads like a mystery.” In her 2021 book, The Lady’s Handbook for Her Mysterious Illness, Sarah Ramey writes that she “Miss Marpled for my life” after a botched procedure left her “undead.” In her new book A Matter of Appearance, Emily Wells likens her body to an “escape room” she can’t quite solve. Allison Behringer’s confessional, critically acclaimed podcast Bodies (tagline: “a show about people solving the mysteries of their bodies”) is now in its fourth season. And sickfluencers dominate TikTok, YouTube, and Instagram. Everyone is their own cold case, waiting impatiently to be solved.
For patients, illness narratives have always been a “final bereavement for all that is left behind and for oneself,” according to Kleinman. The existential threat of a newly diagnosed disease or the onset of symptoms that prove to be chronic may later be interpreted as a line of demarcation—police tape between the true self and the body left behind.
Readers demand evidence of this pain. O’Rourke records a mysterious rash (“I stroked the bumps as if they could spell out a word that would unlock the mystery”). Sick’s feverish structure forces the reader to confront one of Khakpour’s primary symptoms: brain fog. Ramey, in her jocular style, lays out in excruciating detail the urethral dilation that triggered a decade-plus of urologic, gastric, and gynecological pain—or what the author now calls “the elemental facts in the tragically curious case of Sarah M. Ramey.”
But for many, to become chronically ill is to become a stranger to oneself. The patient is robbed of their identity (“I’ve had my entire adult life stolen by an invisible and malicious leviathan,” Ramey writes). They feel they have been left for dead (“I settled into life as a young woman in mourning for her body,” Wells recalls). The ability to describe these experiences—and, often, describe them beautifully—is little consolation for the sudden, spasmodic contraction of the writer’s world.
For the mysteriously ill, friends, family, and health care
providers all too easily assume the role of judge and jury. Ramey meets a
series of disbelieving doctors, including one who storms out of the clinic when
she cries from the pain of a physical exam—and later leaves a note in her
shared medical record accusing her of drug-seeking behaviors. When Emma Bolden,
whose 2022 memoir The
Tiger and the Cage
documents
her endometriosis, is hemorrhaging after a hysterectomy, she can’t get the
doctor who performed the surgery to return her calls. Everyone, it seems, loses
friends en masse over the long and lonely housebound years.
Reasonable doubt is elemental to justice, or so we are told. But sociologist Arthur Frank argues in his treatise The Wounded Storyteller that the real motivation for disbelief may be fear: “All of us on the outside of some chaos want assurances that if we fell in, we could get out,” he writes. For physicians, this inclination to deny the suffering of others is only exacerbated by their training. “The nagging worry is that if you can’t see it objectively, you are missing something medically or being bamboozled somehow—fooled by the patient,” one researcher tells O’Rourke. The myth of the malingerer—an individual who feigns illness and/or refuses to get better for their social or material benefit—remains potent. When doctors can’t name what is afflicting O’Rourke or Khakpour or Ramey, they opt for a simpler solution: antidepressants.
Invalidation is a recurring plot point, the clinical equivalent of a red herring that leads to the premature closing of the case. In many health care settings today, patients are asked to choose between what Frank calls “narrative surrender” to a physician’s interpretation of their body—even as it flies in the face of lived experience—or go it alone.
This was the case for O’Rourke. As her symptoms pile up, she finds that many of the physicians she encounters are unable or unwilling to assist her. “Where the evidence stops,” she later writes, “the doctors’ hands are tied.” Pushed to the margins of medicine, she becomes an indefatigable investigator. She reads academic journals, consults a wide range of healers, and experiments with treatments from the conventional to the cultish. She is often alone and lonely. “In the absence of medical clarity,” O’Rourke writes, “I had to decide what to do.”
Just 50 years ago, it was much harder to pursue one’s own diagnosis in defiance of medical authority: Medical paternalism was the dominant paradigm in American health care; doctors still routinely withheld diagnoses such as cancer from their patients. But in the last half-century, with the retreat of the welfare state, the growth of privatized, profit-driven health care conglomerates, and the steady advance of neoliberalism, patients have been transformed into health care “consumers.” As such, they exercise some degree of choice in the clinic. They’re also left to navigate the system on their own.
For the patient whose experience is doubted by authorities, individual responsibility—and its outward manifestation in investigation—poses a distinct risk. If it works, and a patient arrives at an acceptable diagnosis, they may be able to reintegrate into a society that values scientific legitimacy over personal testimony. Friends and family are more forgiving; doctors are more generous with their prescribing privileges. The patient, even if they are unable to return to full-time productivity, can arrive at some form of closure.
The pitfalls of investigations, however, are many. The health consumer’s quest exposes her to new crimes. Ramey is pushed to the limits by yogis and acupuncturists who insist she has the power to heal herself. O’Rourke still holds complicated feelings about her one-time trial of ozone therapy. At the recommendation of friends, Wells sees a healer who says she is sick because of a “pattern of promiscuous behavior”: “You must have had sex very young,” he says. “When a young woman ignites that fire too soon, it courses through her for the rest of her life.” Questing for answers also costs a fortune, in both time and money. “My full-time job became my health,” Khakpour attests.
At its most extreme, auto-investigation can breed a distinct form of self-obsession. Relentless examination can have unforeseen consequences, as neurologist Suzanne O’Sullivan writes in The Sleeping Beauties, an examination of psychosomatic disorder. Patients’ interpretations of otherwise harmless physical experiences—an upset stomach, a change in vaginal discharge, a variation in heartbeat—may generate new forms of distress. The pain and suffering is not “all in your head,” but some modicum of trust in the body is essential for a peaceful mind.
Emily Wells is, in many ways, the usual suspect. Her mysterious symptoms (“Always: nerve pain, inflamed joints, nausea, fatigue, oral ulcerations, general susceptibility to infection,” she writes in A Matter of Appearance, her debut memoir) stretch back to childhood. She often feels dissociated: “The self that observes its own illness for a long period of time is vulnerable to that mind-body split.” Even when Wells arrives at a widely accepted diagnosis—of an incurable inflammatory illness known as Behcet’s disease—she knows no peace. Diagnoses “are means to the end of accessing care,” she writes of such labels, “not ends in themselves.” So Wells, a crime reporter for a regional paper,* throws herself into another medical mystery, interweaving her own case with that of Louise Augustine Gleizes, the face of nineteenth-century hysteria.
Little is known about
Augustine’s life, though Wells writes empathetically into the void. Augustine
arrived at the Salpêtrière Hospital in Paris at age 14, the victim of repeated
sexual abuse. There, the nineteenth-century neurologist Jean-Martin Charcot would
hypnotize her for audiences, which included the psychiatrist Sigmund Freud and
the painter Edgar Degas, so Augustine could demonstrate the dramatic poses that
typified her disease. It’s the photos of these sessions by Paul Regnard—some
tightly composed, like mug shots, others threatening to spill out over the
edges, like a crime scene—that preserved Augustine in memory.
Wells keeps these images close at hand. For the author,
Augustine appears to represent the gendered violence that has structured
Wells’s life, from her adolescent commitment to ballet to her ongoing dance
with biomedicine. “The picture of a symptom, a medical riddle, is the form her
life has taken,” she writes of Augustine. But Augustine also offers a point of
contact with other bodies, both sick and well, living and dead. “The sick person
examining only her own suffering does so without a sense of history,” Wells
writes. She keeps the magnifying glass in hand, but she focuses it on something
new.
Like true crime, the patient memoir seeks to impose a logic on a world teeming with violence. A good narrative—whether shared in a book or between friends—can restore some semblance of order on a life that has ceased to make sense. There have never been more tools at the sick person’s disposal, whether they’re in the earliest stages of googling or recovered enough to begin sharing their streamlined story on social media. But care, the very foundation of well-being, remains elusive: The social safety net is full of holes. Everyone is by necessity an armchair expert. And doctors who will really listen are hard to find. The patient-detective is not to blame for the mystery that is her body; her memoirs are a powerful indictment.
* An earlier version of this article misstated the paper for which Wells worked.